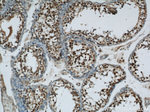
MORF4L1 Antibody in Immunohistochemistry (Paraffin) (IHC (P))
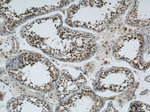
MORF4L1 Antibody in Immunohistochemistry (Paraffin) (IHC (P))
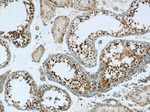
MORF4L1 Antibody in Immunohistochemistry (Paraffin) (IHC (P))

Search
Proteintech
MORF4L1 Polyclonal Antibody
{{$productOrderCtrl.translations['antibody.pdp.commerceCard.promotion.promotions']}}
{{$productOrderCtrl.translations['antibody.pdp.commerceCard.promotion.viewpromo']}}
{{$productOrderCtrl.translations['antibody.pdp.commerceCard.promotion.promocode']}}: {{promo.promoCode}} {{promo.promoTitle}} {{promo.promoDescription}}. {{$productOrderCtrl.translations['antibody.pdp.commerceCard.promotion.learnmore']}}
产品信息
55257-1-AP
种属反应
宿主/亚型
分类
类型
抗原
偶联物
形式
浓度
规格
纯化类型
保存液
内含物
保存条件
运输条件
产品详细信息
This antibody has no cross-reaction to MORF4L2.
靶标信息
MRG15 ia a component of the NuA4 histone acetyltransferase (HAT) complex which is involved in transcriptional activation of select genes principally by acetylation of nucleosomal histone H4 and H2A. This modification may both alter nucleosome-DNA interactions and promote interaction of the modified histones with other proteins which positively regulate transcription. This complex may be required for the activation of transcriptional programs associated with oncogene and proto-oncogene mediated growth induction, tumor suppressor mediated growth arrest and replicative senescence, apoptosis and DNA repair.
仅用于科研。不用于诊断过程。未经明确授权不得转售。
篇参考文献 (0)
生物信息学
蛋白别名: Esa1p-associated factor 3 homolog; MGC10631; MORF-related gene 15 protein; MORF-related gene on chromosome 15; Mortality factor 4-like protein 1; MRG15; Protein MSL3-1; S863-6; testis expressed gene 189; Testis-expressed gene 189 protein; Transcription factor-like protein MRG15; unnamed protein product
基因别名: Eaf3; FWP006; HSPC008; HSPC061; HsT17725; MEAF3; mKIAA4002; MORF4L1; MORFRG15; MRG15; PP368; S863-6; TEG-189; Tex189
UniProt ID: (Human) Q9UBU8, (Rat) Q6AYU1, (Mouse) P60762
Entrez Gene ID: (Human) 10933, (Rat) 300891, (Mouse) 21761